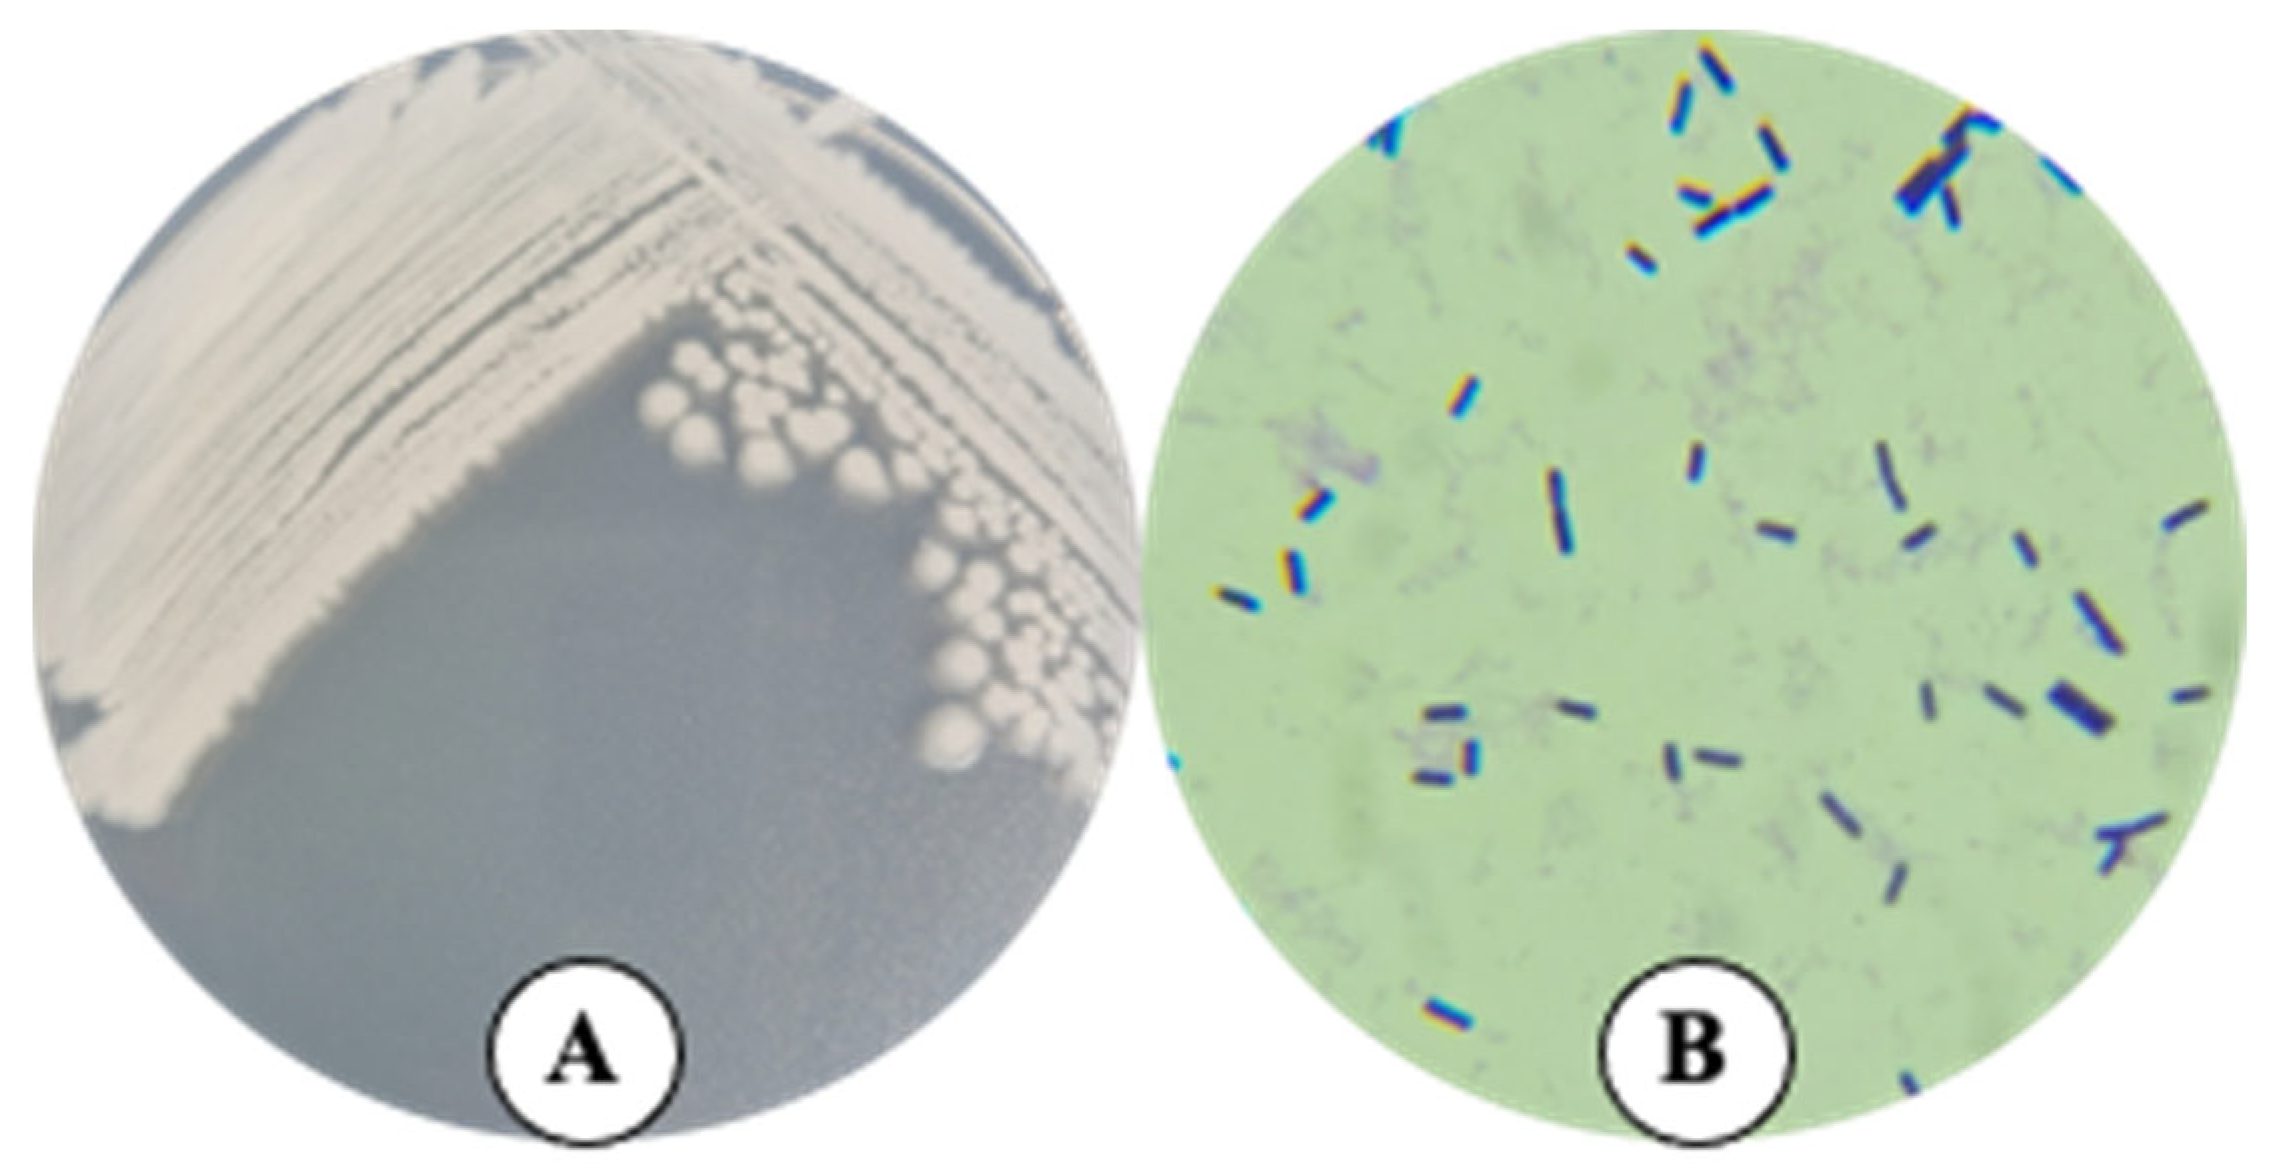
Plants 14 01019 g001

Do Organic Amendments Foster Only Beneficial Bacteria in Agroecosystems?: The Case of Bacillus paranthracis TSO55
Abstract
1. Introduction
2. Results
2.1. Morphology of Strain TSO55
2.2. Genomic Analysis
2.3. Genome Annotation and Genome Mining
2.4. In Vitro Evaluation of Predicted Traits of Strain TSO55: Plant Growth Promotion, Biocontrol, Antibiotic Susceptibility, and Pathogenicity
2.5. In Vivo Impact of Strain TSO55 on Wheat Growth
3. Discussion
4. Materials and Methods
4.1. Bacterial Isolation and Morphological Characterization
4.2. Genomic Analysis
4.3. Genome Annotation and Genome Mining
4.4. In Vitro Evaluation of Predicted Traits of Strain TSO55: Plant Growth Promotion, Biocontrol, Antibiotic Susceptibility, and Pathogenicity
4.5. In Vivo Impact of Strain TSO55 on Wheat Growth
5. Conclusions
Author Contributions
Funding
Data Availability Statement
Acknowledgments
Conflicts of Interest
References
- Santini, N.S.; Cuervo-Robayo, A.P.; Adame, M.F. Agricultural Land Degradation in Mexico. In Handbook of Environmental Chemistry; Springer: Cham, Switzerland, 2023; Volume 120, pp. 301–323. ISBN 978-3-031-32168-9. [Google Scholar]
- Sindhu, V.; Chatterjee, R.; Santhoshkumar, G.M.; Sinha, T. Enrichment of Organic Manures and Their Utilization in Vegetable Crops. Curr. J. Appl. Sci. Technol. 2020, 39, 10–24. [Google Scholar] [CrossRef]
- Ibarra-Villarreal, A.L.; Parra-Cota, F.I.; Yepez, E.A.; Gutiérrez-Coronado, M.A.; Valdez-Torres, L.C.; de los Santos-Villalobos, S. Impact of a Shift from Conventional to Organic Wheat Farming on Soil Cultivable Fungal Communities in the Yaqui Valley, Mexico. Impacto Del Cambio En El Manejo Del Cultivo de Trigo de Convencional a Orgánico Sobre Las Comunidades Fúngicas Cultivables Del. Agrociencia 2020, 54, 643–659. [Google Scholar]
- Goldan, E.; Nedeff, V.; Barsan, N.; Culea, M.; Panainte-Lehadus, M.; Mosnegutu, E.; Tomozei, C.; Chitimus, D.; Irimia, O. Assessment of Manure Compost Used as Soil Amendment—A Review. Processes 2023, 11, 1167. [Google Scholar] [CrossRef]
- Zhu, L.; Lian, Y.; Lin, D.; Huang, D.; Yao, Y.; Ju, F.; Wang, M. Insights into Microbial Contamination in Multi-Type Manure-Amended Soils: The Profile of Human Bacterial Pathogens, Virulence Factor Genes and Antibiotic Resistance Genes. J. Hazard. Mater. 2022, 437, 129356. [Google Scholar] [CrossRef]
- Akanmu, A.O.; Babalola, O.O.; Venturi, V.; Ayilara, M.S.; Adeleke, B.S.; Amoo, A.E.; Sobowale, A.A.; Fadiji, A.E.; Glick, B.R. Plant Disease Management: Leveraging on the Plant-Microbe-Soil Interface in the Biorational Use of Organic Amendments. Front. Plant Sci. 2021, 12, 700507. [Google Scholar] [CrossRef]
- Li, J.; Chen, Q.; Li, H.; Li, S.; Liu, Y.; Yang, L.; Han, X. Impacts of Different Sources of Animal Manures on Dissemination of Human Pathogenic Bacteria in Agricultural Soils. Environ. Pollut. 2020, 266, 115399. [Google Scholar] [CrossRef] [PubMed]
- Schierstaedt, J.; Grosch, R.; Schikora, A. Agricultural Production Systems Can Serve as Reservoir for Human Pathogens. FEMS Microbiol. Lett. 2019, 366, fnaa016. [Google Scholar] [CrossRef]
- Goss, M.J.; Tubeileh, A.; Goorahoo, D. A Review of the Use of Organic Amendments and the Risk to Human Health. In Advances in Agronomy; Academic Press: Cambridge, MA, USA, 2013; Volume 120, pp. 275–379. [Google Scholar]
- Yan, Z.; Xiong, C.; Liu, H.; Singh, B.K. Sustainable Agricultural Practices Contribute Significantly to One Health. J. Sustain. Agric. Environ. 2022, 1, 165–176. [Google Scholar] [CrossRef]
- Doddabematti Prakash, S.; Rivera, J.; Sabillón, L.; Siliveru, K. From Wheat Grain to Flour: A Review of Potential Sources of Enteric Pathogen Contamination in Wheat Milled Products. Crit. Rev. Food Sci. Nutr. 2024. [Google Scholar] [CrossRef]
- Rivera, J.; Shivaprasad, D.P.; Sabillón, L.; Siliveru, K. Enteric Pathogen Survival, Food Safety Incidents, and Potential Mitigation Strategies to Address Microbial Contamination in Wheat-Based Foods: A Review. Crit. Rev. Food Sci. Nutr. 2024. [Google Scholar] [CrossRef]
- Jessberger, N.; Dietrich, R.; Granum, P.E.; Märtlbauer, E. The Bacillus Cereus Food Infection as Multifactorial Process. Toxins 2020, 12, 701. [Google Scholar] [CrossRef] [PubMed]
- Bamdad, H.; Papari, S.; Lazarovits, G.; Berruti, F. Soil Amendments for Sustainable Agriculture: Microbial Organic Fertilizers. Soil Use Manag. 2022, 38, 94–120. [Google Scholar]
- Ballardo, C.; Vargas-García, M.d.C.; Sánchez, A.; Barrena, R.; Artola, A. Adding Value to Home Compost: Biopesticide Properties through Bacillus Thuringiensis Inoculation. Waste Manag. 2020, 106, 32–43. [Google Scholar] [CrossRef]
- Bektas, I.; Kusek, M. Biological Control of Onion Basal Rot Disease Using Phosphate Solubilising Rhizobacteria. Biocontrol Sci. Technol. 2021, 31, 190–205. [Google Scholar] [CrossRef]
- Abo-Elyousr, K.A.M.; Abdel-Rahim, I.R.; Almasoudi, N.M.; Alghamdi, S.A. Native Endophytic Pseudomonas Putida as a Biocontrol Agent against Common Bean Rust Caused by Uromyces Appendiculatus. J. Fungi 2021, 7, 745. [Google Scholar] [CrossRef]
- Belousova, M.E.; Malovichko, Y.V.; Shikov, A.E.; Nizhnikov, A.A.; Antonets, K.S. Dissecting the Environmental Consequences of Bacillus Thuringiensis Application for Natural Ecosystems. Toxins 2021, 13, 355. [Google Scholar] [CrossRef]
- Zhou, H.; Ren, Z.H.; Zu, X.; Yu, X.Y.; Zhu, H.J.; Li, X.J.; Zhong, J.; Liu, E.M. Efficacy of Plant Growth-Promoting Bacteria Bacillus Cereus YN917 for Biocontrol of Rice Blast. Front. Microbiol. 2021, 12, 684888. [Google Scholar] [CrossRef]
- Parke, J.L.; Gurian-Sherman, D. Diversity of the Burkholderia Cepacia Complex and Implications for Risk Assessment of Biological Control Strains. Annu. Rev. Phytopathol. 2001, 39, 225–258. [Google Scholar] [PubMed]
- Salazar, B.; Ortiz, A.; Keswani, C.; Minkina, T.; Mandzhieva, S.; Pratap Singh, S.; Rekadwad, B.; Borriss, R.; Jain, A.; Singh, H.B.; et al. Bacillus Spp. as Bio-Factories for Antifungal Secondary Metabolites: Innovation Beyond Whole Organism Formulations. Microb. Ecol. 2023, 86, 1–24. [Google Scholar] [CrossRef]
- Etesami, H.; Jeong, B.R.; Glick, B.R. Potential Use of Bacillus Spp. as an Effective Biostimulant against Abiotic Stresses in Crops—A Review. Curr. Res. Biotechnol. 2023, 5, 100128. [Google Scholar] [CrossRef]
- Villarreal-Delgado, M.F.; Villa-Rodríguez, E.D.; Cira-Chávez, L.A.; Estrada-Alvarado, M.I.; Parra-Cota, F.I.; De los Santos-Villalobos, S. The Genus Bacillus as a Biological Control Agent and Its Implications in the Agricultural Biosecurity. Mex. J. Phytopathol. 2018, 36, 95–130. [Google Scholar] [CrossRef]
- Valenzuela-Ruiz, V.; Miranda-Carrazco, A.M.; Parra Cota, F.I.; de los Santos Villalobos, S. Polyphasic Taxonomy of Strains in Bacterial Inoculants. In New Insights, Trends, and Challenges in the Development and Applications of Microbial Inoculants in Agriculture; Academic Press: Cambridge, MA, USA, 2024; pp. 87–97. ISBN 9780443188558. [Google Scholar]
- Córdova-Albores, L.C.; Zelaya-Molina, L.X.; Ávila-Alistac, N.; Valenzuela-Ruíz, V.; Cortés-Martínez, N.E.; Parra-Cota, F.I.; Burgos-Canul, Y.Y.; Chávez-Díaz, I.F.; Fajardo-Franco, M.L.; De los Santos-Villalobos, S. Omics Sciences Potential on Bioprospecting of Biological Control Microbial Agents: The Case of the Mexican Agro-Biotechnology. Rev. Mex. Fitopatol. Mex. J. Phytopathol. 2020, 39, 147–184. [Google Scholar] [CrossRef]
- Morales Sandoval, P.H.; Valenzuela Ruiz, V.; Ortega Urquieta, M.E.; Denisse Martínez Vidales, A.; María, C.; Pablos, F.; Alejandro Chávez Luzania, R.; Parra Cota, F.I.; de los Santos Villalobos, S. Taxonomía bacteriana basada en Índices relacionados al genoma completo. In La Sociedad Académica; Instituto Tecnológico de Sonora: Obregón, México, 2021; pp. 39–50. [Google Scholar]
- Gokul, A.; Mabaso, J.; Henema, N.; Otomo, L.; Bakare, O.O.; Klein, A.; Daniel, A.I.; Omolola, A.; Niekerk, L.A.; Nkomo, M.; et al. Sustainable Agriculture through the Enhancement of Microbial Biocontrol Agents: Current Challenges and New Perspectives. Appl. Sci. 2023, 13, 6507. [Google Scholar] [CrossRef]
- Villa-Rodriguez, E.; Moreno-Ulloa, A.; Castro-Longoria, E.; Parra-Cota, F.I.; de los Santos-Villalobos, S. Integrated Omics Approaches for Deciphering Antifungal Metabolites Produced by a Novel Bacillus Species, B. Cabrialesii TE3T, against the Spot Blotch Disease of Wheat (Triticum turgidum L. Subsp. Durum). Microbiol. Res. 2021, 251, 126826. [Google Scholar] [CrossRef] [PubMed]
- Campos-Avelar, I.; Montoya-Martínez, A.C.; Villa-Rodríguez, E.D.; Valenzuela-Ruiz, V.; Zepeda, M.A.; Parra-Cota, F.I.; Villalobos, S.d.S. The Mitigation of Phytopathogens in Wheat under Current and Future Climate Change Scenarios: Next-Generation Microbial Inoculants. Sustainability 2023, 15, 15250. [Google Scholar] [CrossRef]
- Lefort, V.; Desper, R.; Gascuel, O. FastME 2.0: A Comprehensive, Accurate, and Fast Distance-Based Phylogeny Inference Program. Mol. Biol. Evol. 2015, 32, 2798–2800. [Google Scholar] [CrossRef]
- Farris, J.S. Estimating Phylogenetic Trees from Distance Matrices. Am. Nat. 1972, 106, 645–668. [Google Scholar] [CrossRef]
- Borriss, R. Bacillus. In Beneficial Microbes in Agro-Ecology: Bacteria and Fungi; Academic Press: Cambridge, MA, USA, 2020; pp. 107–132. ISBN 9780128234143. [Google Scholar]
- Logan, N.A.; Vos, P. De Bacillus. In Bergey’s Manual of Systematics of Archaea and Bacteria; John Wiley & Sons, Inc.: Hoboken, NJ, USA, 2015; pp. 1–163. [Google Scholar] [CrossRef]
- Du, Y.; Qian, C.; Li, X.; Zheng, X.; Huang, S.; Yin, Z.; Chen, T.; Pan, L. Unveiling Intraspecific Diversity and Evolutionary Dynamics of the Foodborne Pathogen Bacillus Paranthracis through High-Quality Pan-Genome Analysis. Curr. Res. Food Sci. 2024, 9, 100867. [Google Scholar] [CrossRef]
- Carroll, L.M.; Cheng, R.A.; Wiedmann, M.; Kovac, J. Keeping up with the Bacillus Cereus Group: Taxonomy through the Genomics Era and Beyond. Crit. Rev. Food Sci. Nutr. 2022, 62, 7677–7702. [Google Scholar] [CrossRef]
- Sokolov, S.; Brovko, F.; Solonin, A.; Nikanova, D.; Fursova, K.; Artyemieva, O.; Kolodina, E.; Sorokin, A.; Shchannikova, M.; Dzhelyadin, T.; et al. Genomic Analysis and Assessment of Pathogenic (Toxicogenic) Potential of Staphylococcus Haemolyticus and Bacillus Paranthracis Consortia Isolated from Bovine Mastitis in Russia. Sci. Rep. 2023, 13, 18646. [Google Scholar] [CrossRef]
- Baev, V.; Iliev, I.; Stefanov, Y.; Tsankova, M.; Marhova, M.; Apostolova, E.; Gozmanova, M.; Yahubyan, G.; Kostadinova, S. Exploring the Genomic Landscape of Bacillus Paranthracis PUMB_17 as a Proficient Phosphatidylcholine-Specific Phospholipase C Producer. Curr. Issues Mol. Biol. 2024, 46, 2497–2513. [Google Scholar] [CrossRef] [PubMed]
- Valenzuela Ruiz, V.; Santoyo, G.; Gómez Godínez, L.J.; Cira Chávez, L.A.; Parra Cota, F.I.; de los Santos Villalobos, S. Complete Genome Sequencing of Bacillus Cabrialesii TE3T: A Plant Growth-Promoting and Biological Control Agent Isolated from Wheat (Triticum Turgidum Subsp. Durum) in the Yaqui Valley. Curr. Res. Microb. Sci. 2023, 4, 100193. [Google Scholar] [CrossRef]
- Dimopoulou, A.; Theologidis, I.; Benaki, D.; Koukounia, M.; Zervakou, A.; Tzima, A.; Diallinas, G.; Hatzinikolaou, D.G.; Skandalis, N. Direct Antibiotic Activity of Bacillibactin Broadens the Biocontrol Range of Bacillus Amyloliquefaciens MBI600. mSphere 2021, 6, e00376-21. [Google Scholar] [CrossRef]
- Yadav, V.K.; Yadav, R.C.; Choudhary, P.; Sharma, S.K.; Bhagat, N. Mitigation of Drought Stress in Wheat (Triticum aestivum L.) by Inoculation of Drought Tolerant Bacillus Paramycoides DT-85 and Bacillus Paranthracis DT-97. J. Appl. Biol. Biotechnol. 2022, 10, 59–69. [Google Scholar] [CrossRef]
- Liu, J.; Qin, D.; Huang, W.; Wang, X.; Li, Y.; Zhang, R. Biocontrol Ability and Action Mechanism of Bacillus Amyloliquefaciens Baf1 against Fusarium Incarnatum Causing Fruit Rot in Postharvest Muskmelon (Cv. Yugu) Fruit. LWT 2023, 181, 114714. [Google Scholar] [CrossRef]
- Morandini, L.; Caulier, S.; Bragard, C.; Mahillon, J. Bacillus Cereus Sensu Lato Antimicrobial Arsenal: An Overview. Microbiol. Res. 2024, 283, 127697. [Google Scholar] [CrossRef]
- Liu, Y.; Du, J.; Lai, Q.; Zeng, R.; Ye, D.; Xu, J.; Shao, Z. Proposal of Nine Novel Species of the Bacillus Cereus Group. Int. J. Syst. Evol. Microbiol. 2017, 67, 2499–2508. [Google Scholar] [CrossRef] [PubMed]
- de Sousa, L.P. Genomic and Pathogenicity of a Bacillus Paranthracis Isolated from Book Page Surface. Infect. Genet. Evol. 2021, 92, 104867. [Google Scholar] [CrossRef]
- Sornchuer, P.; Saninjuk, K.; Amonyingcharoen, S.; Ruangtong, J.; Thongsepee, N.; Martviset, P.; Chantree, P.; Sangpairoj, K. Whole Genome Sequencing Reveals Antimicrobial Resistance and Virulence Genes of Both Pathogenic and Non-Pathogenic B. Cereus Group Isolates from Foodstuffs in Thailand. Antibiotics 2024, 13, 245. [Google Scholar] [CrossRef]
- Abdelli, M.; Falaise, C.; Morineaux-Hilaire, V.; Cumont, A.; Taysse, L.; Raynaud, F.; Ramisse, V. Get to Know Your Neighbors: Characterization of Close Bacillus Anthracis Isolates and Toxin Profile Diversity in the Bacillus Cereus Group. Microorganisms 2023, 11, 2721. [Google Scholar] [CrossRef]
- Diale, M.O.; Kayitesi, E.; Serepa-Dlamini, M.H. Genome In Silico and In Vitro Analysis of the Probiotic Properties of a Bacterial Endophyte, Bacillus Paranthracis Strain MHSD3. Front. Genet. 2021, 12, 672149. [Google Scholar] [CrossRef]
- Aly, A.A.; El-Mahdy, O.M.; Habeb, M.M.; Elhakem, A.; Asran, A.A.; Youssef, M.M.; Mohamed, H.I.; Hanafy, R.S. Pathogenicity of Bacillus Strains to Cotton Seedlings and Their Effects on Some Biochemical Components of the Infected Seedlings. Plant Pathol. J. 2022, 38, 90–101. [Google Scholar] [CrossRef] [PubMed]
- Wang, S.; Xie, H.; Liu, L.; Du, L.; Yin, F.; Chen, Y.; Liu, Z.; Sun, G.; Zhang, X.; Sun, D.; et al. A Rare Waterborne Outbreak of Bacillus Paranthracis in Shandong Province, China, 2020: Epidemiologic Survey, Genomic Insights, and Virulence Characteristics. Emerg. Microbes Infect. 2024, 13, 2348498. [Google Scholar] [CrossRef] [PubMed]
- Carroll, L.M.; Wiedmann, M.; Mukherjee, M.; Nicholas, D.C.; Mingle, L.A.; Dumas, N.B.; Cole, J.A.; Kovac, J. Characterization of Emetic and Diarrheal Bacillus Cereus Strains from a 2016 Foodborne Outbreak Using Whole-Genome Sequencing: Addressing the Microbiological, Epidemiological, and Bioinformatic Challenges. Front. Microbiol. 2019, 10, 144. [Google Scholar] [CrossRef] [PubMed]
- Tshisikhawe, M.L.; Diale, M.O.; Abrahams, A.M.; Serepa-Dlamini, M.H. Screening and Production of Industrially Relevant Enzymes by Bacillus Paranthracis Strain MHDS3, a Potential Probiotic. Fermentation 2023, 9, 938. [Google Scholar] [CrossRef]
- Magid, J.; Pedersen, K.E.; Hansen, M.; Cedergreen, N.; Brandt, K.K. Comparative Assessment of the Risks Associated with Use of Manure and Sewage Sludge in Danish Agriculture. In Advances in Agronomy; Academic Press: Cambridge, MA, USA, 2020; Volume 164, pp. 289–334. ISBN 9780128207710. [Google Scholar]
- Ibarra-Villarreal, A.L.; Gándara-Ledezma, A.; Godoy-Flores, A.; Díaz-Rodríguez, A.M.; Parra-Cota, F.I.; de los Santos-Villalobos, S. Salt-Tolerant Bacillus Species as a Promising Strategy to Mitigate the Salinity Stress in Wheat (Triticum turgidum Subsp Durum). J. Arid Environ. 2021, 186, 104399. [Google Scholar] [CrossRef]
- de los Santos-Villalobos, S.; Díaz-Rodríguez, A.M.; Ávila-Mascareño, M.F.; Martínez-Vidales, A.D.; Parra-Cota, F.I. COLMENA: A Culture Collection of Native Microorganisms for Harnessing the Agro-Biotechnological Potential in Soils and Contributing to Food Security. Diversity 2021, 13, 337. [Google Scholar] [CrossRef]
- de los Santos-Villalobos, S. Colección de Microorganismos Edáficos y Endófitos Nativos (COLMENA). Available online: https://www.itson.mx/micrositios/colmena/Paginas/informacion.aspx (accessed on 21 October 2024).
- Valenzuela-Aragon, B.; Montoya-Martínez, A.C.; Parra-Cota, F.I.; de los Santos-Villalobos, S. Genomic Insight into a Potential Biological Control Agent for Fusarium-Related Diseases in Potatoes: Bacillus Cabrialesii Subsp. Cabrialesii Strain PE1. Horticulturae 2024, 10, 357. [Google Scholar] [CrossRef]
- Ortega-Urquieta, M.E.; Valenzuela-Ruíz, V.; Mitra, D.; Hyder, S.; Elsheery, N.I.; Kumar Das Mohapatra, P.; Parra-Cota, F.I.; de los Santos-Villalobos, S. Draft Genome Sequence of Priestia Sp. Strain TSO9, a Plant Growth-Promoting Bacterium Associated with Wheat (Triticum turgidum Subsp. Durum) in the Yaqui Valley, Mexico. Plants 2022, 11, 2231. [Google Scholar] [CrossRef]
- Bolger, A.M.; Lohse, M.; Usadel, B. Trimmomatic: A Flexible Trimmer for Illumina Sequence Data. Bioinformatics 2014, 30, 2114–2120. [Google Scholar] [CrossRef]
- Bankevich, A.; Nurk, S.; Antipov, D.; Gurevich, A.A.; Dvorkin, M.; Kulikov, A.S.; Lesin, V.M.; Nikolenko, S.I.; Pham, S.; Prjibelski, A.D.; et al. SPAdes: A New Genome Assembly Algorithm and Its Applications to Single-Cell Sequencing. J. Comput. Biol. 2012, 19, 455–477. [Google Scholar] [CrossRef] [PubMed]
- Prjibelski, A.; Antipov, D.; Meleshko, D.; Lapidus, A.; Korobeynikov, A. Using SPAdes De Novo Assembler. Curr. Protoc. Bioinforma. 2020, 70, e102. [Google Scholar] [CrossRef] [PubMed]
- Darling, A.C.E.; Mau, B.; Blattner, F.R.; Perna, N.T. Mauve: Multiple Alignment of Conserved Genomic Sequence with Rearrangements. Genome Res. 2004, 14, 1394–1403. [Google Scholar] [CrossRef]
- Rissman, A.I.; Mau, B.; Biehl, B.S.; Darling, A.E.; Glasner, J.D.; Perna, N.T. Reordering Contigs of Draft Genomes Using the Mauve Aligner. Bioinformatics 2009, 25, 2071–2073. [Google Scholar] [CrossRef] [PubMed]
- Carattoli, A.; Zankari, E.; Garciá-Fernández, A.; Larsen, M.V.; Lund, O.; Villa, L.; Aarestrup, F.M.; Hasman, H. In Silico Detection and Typing of Plasmids Using Plasmidfinder and Plasmid Multilocus Sequence Typing. Antimicrob. Agents Chemother. 2014, 58, 3895–3903. [Google Scholar] [CrossRef]
- Centre for Genomic Epidemiology PlasmidFinder 2.1. Available online: https://cge.food.dtu.dk/services/PlasmidFinder/ (accessed on 21 October 2024).
- Parks, D.H.; Imelfort, M.; Skennerton, C.T.; Hugenholtz, P.; Tyson, G.W. CheckM: Assessing the Quality of Microbial Genomes Recovered from Isolates, Single Cells, and Metagenomes. Genome Res. 2015, 25, 1043–1055. [Google Scholar] [CrossRef]
- Gurevich, A.; Saveliev, V.; Vyahhi, N.; Tesler, G. QUAST: Quality Assessment Tool for Genome Assemblies. Bioinformatics 2013, 29, 1072–1075. [Google Scholar] [CrossRef]
- Yoon, S.H.; Ha, S.m.; Lim, J.; Kwon, S.; Chun, J. A Large-Scale Evaluation of Algorithms to Calculate Average Nucleotide Identity. Antonie Van Leeuwenhoek 2017, 110, 1281–1286. [Google Scholar] [CrossRef]
- Meier-Kolthoff, J.P.; Auch, A.F.; Klenk, H.P.; Göker, M. Genome Sequence-Based Species Delimitation with Confidence Intervals and Improved Distance Functions. BMC Bioinform. 2013, 14, 60. [Google Scholar] [CrossRef]
- Meier-Kolthoff, J.P.; Carbasse, J.S.; Peinado-Olarte, R.L.; Göker, M. TYGS and LPSN: A Database Tandem for Fast and Reliable Genome-Based Classification and Nomenclature of Prokaryotes. Nucleic Acids Res. 2022, 50, D801–D807. [Google Scholar] [CrossRef]
- Meier-Kolthoff, J.P.; Göker, M. TYGS Is an Automated High-Throughput Platform for State-of-the-Art Genome-Based Taxonomy. Nat. Commun. 2019, 10, 2182. [Google Scholar] [CrossRef] [PubMed]
- Leibniz Institute DSMZ. TYGS Type Strain Genome Server; Leibniz Institute DSMZ: Braunschweig, Germany, 2019; pp. 1–12. [Google Scholar]
- Aziz, R.K.; Bartels, D.; Best, A.; DeJongh, M.; Disz, T.; Edwards, R.A.; Formsma, K.; Gerdes, S.; Glass, E.M.; Kubal, M.; et al. The RAST Server: Rapid Annotations Using Subsystems Technology. BMC Genom. 2008, 9, 75. [Google Scholar] [CrossRef]
- Overbeek, R.; Olson, R.; Pusch, G.D.; Olsen, G.J.; Davis, J.J.; Disz, T.; Edwards, R.A.; Gerdes, S.; Parrello, B.; Shukla, M.; et al. The SEED and the Rapid Annotation of Microbial Genomes Using Subsystems Technology (RAST). Nucleic Acids Res. 2014, 42, D206–D214. [Google Scholar] [CrossRef] [PubMed]
- Rapid Annotation using Subsystem Technology RAST Server-RAST Annotation Server. Available online: https://rast.nmpdr.org/ (accessed on 21 October 2024).
- Grant, J.R.; Enns, E.; Marinier, E.; Mandal, A.; Herman, E.K.; Chen, C.Y.; Graham, M.; Van Domselaar, G.; Stothard, P. Proksee: In-Depth Characterization and Visualization of Bacterial Genomes. Nucleic Acids Res. 2023, 51, W484–W492. [Google Scholar] [CrossRef]
- Grant, J.R.; Enns, E.; Marinier, E.; Mandal, A.; Herman, E.K.; Chen, C.Y.; Graham, M.; Van Domselaar, G.; Stothard, P. Proksee-Genome Analysis. Available online: https://proksee.ca/ (accessed on 21 October 2024).
- Seemann, T. Prokka: Rapid Prokaryotic Genome Annotation. Bioinformatics 2014, 30, 2068–2069. [Google Scholar] [CrossRef] [PubMed]
- Alcock, B.P.; Huynh, W.; Chalil, R.; Smith, K.W.; Raphenya, A.R.; Wlodarski, M.A.; Edalatmand, A.; Petkau, A.; Syed, S.A.; Tsang, K.K.; et al. CARD 2023: Expanded Curation, Support for Machine Learning, and Resistome Prediction at the Comprehensive Antibiotic Resistance Database. Nucleic Acids Res. 2023, 51, D690–D699. [Google Scholar] [CrossRef]
- Patz, S.; Gautam, A.; Becker, M.; Ruppel, S.; Rodríguez-Palenzuela, P.; Huson, D. PLaBAse: A Comprehensive Web Resource for Analyzing the Plant Growth-Promoting Potential of Plant-Associated Bacteria. bioRxiv 2021. [Google Scholar] [CrossRef]
- Patz, S.; Gautam, A.; Huson, D.H. PLaBAse. Available online: https://plabase.cs.uni-tuebingen.de/pb/plabase.php (accessed on 21 October 2024).
- Blin, K.; Shaw, S.; Augustijn, H.E.; Reitz, Z.L.; Biermann, F.; Alanjary, M.; Fetter, A.; Terlouw, B.R.; Metcalf, W.W.; Helfrich, E.J.N.; et al. AntiSMASH 7.0: New and Improved Predictions for Detection, Regulation, Chemical Structures and Visualisation. Nucleic Acids Res. 2023, 51, W46–W50. [Google Scholar] [CrossRef]
- Blin, K.; Shaw, S.; Kloosterman, A.M.; Charlop-Powers, Z.; van Weezel, G.P.; Medema, M.H. Weber AntiSMASH Bacterial Version. Available online: https://antismash.secondarymetabolites.org/#!/start (accessed on 21 October 2024).
- Cosentino, S.; Voldby Larsen, M.; Møller Aarestrup, F.; Lund, O. PathogenFinder-Distinguishing Friend from Foe Using Bacterial Whole Genome Sequence Data. PLoS ONE 2013, 8, e77302. [Google Scholar] [CrossRef]
- Bortolaia, V.; Kaas, R.S.; Ruppe, E.; Roberts, M.C.; Schwarz, S.; Cattoir, V.; Philippon, A.; Allesoe, R.L.; Rebelo, A.R.; Florensa, A.F.; et al. ResFinder 4.0 for Predictions of Phenotypes from Genotypes. J. Antimicrob. Chemother. 2020, 75, 3491–3500. [Google Scholar] [CrossRef]
- Morales Sandoval, P.H.; Ortega Urquieta, M.E.; Valenzuela Ruíz, V.; Montañez Acosta, K.; Campos Castro, K.A.; Parra Cota, F.I.; Santoyo, G.; de los Santos Villalobos, S. Improving Beneficial Traits in Bacillus Cabrialesii Subsp. Cabrialesii TE3T through UV-Induced Genomic Changes. Plants 2024, 13, 2578. [Google Scholar] [CrossRef]
- Figueredo, E.F.; Cruz, T.A.d.; Almeida, J.R.d.; Batista, B.D.; Marcon, J.; Andrade, P.A.M.d.; Hayashibara, C.A.d.A.; Rosa, M.S.; Azevedo, J.L.; Quecine, M.C. The Key Role of Indole-3-Acetic Acid Biosynthesis by Bacillus Thuringiensis RZ2MS9 in Promoting Maize Growth Revealed by the IpdC Gene Knockout Mediated by the CRISPR-Cas9 System. Microbiol. Res. 2023, 266, 127218. [Google Scholar] [CrossRef]
- Raji, M.; Thangavelu, M. Isolation and Screening of Potassium Solubilizing Bacteria from Saxicolous Habitat and Their Impact on Tomato Growth in Different Soil Types. Arch. Microbiol. 2021, 203, 3147–3161. [Google Scholar] [CrossRef]
- Duveiller, E.; Altamirano, I.G. Pathogenicity of Bipolaris Sorokiniana Isolates from Wheat Roots, Leaves and Grains in Mexico. Plant Pathol. 2000, 49, 235–242. [Google Scholar] [CrossRef]
- Al-Sadi, A.M. Bipolaris Sorokiniana-Induced Black Point, Common Root Rot, and Spot Blotch Diseases of Wheat: A Review. Front. Cell. Infect. Microbiol. 2021, 11, 584899. [Google Scholar] [CrossRef] [PubMed]
- Soylu, S.; Atay, M.; Kara, M.; Uysal, A.; Soylu, E.M.; Kurt, Ş. Morphological and Molecular Characterization of Fusarium Incarnatum as a Causal Disease Agent of Pepper (Capsicum annuum) Fruit Rot. J. Phytopathol. 2023, 171, 688–699. [Google Scholar] [CrossRef]
- Sakiyo, J.J.; Németh, Á. The Potential of Bacilli-Derived Biosurfactants as an Additive for Biocontrol against Alternaria Alternata Plant Pathogenic Fungi. Microorganisms 2023, 11, 707. [Google Scholar] [CrossRef] [PubMed]
- Montoya-Martínez, A.C.; Figueroa-Brambila, K.M.; Escalante-Beltrán, A.; López-Montoya, N.D.; Valenzuela-Ruíz, V.; Parra-Cota, F.I.; Estrada Alvarado, M.I.; de los Santos-Villalobos, S. Biological Control Mechanisms of Bacillus Cabrialesii Subsp. Tritici TSO2T against Fusarium Languescens, the Causal Agent of Wilt in Jalapeño Peppers. Horticulturae 2023, 9, 964. [Google Scholar] [CrossRef]
- Campos-Avelar, I.; Colas de la Noue, A.; Durand, N.; Fay, B.; Martinez, V.; Fontana, A.; Strub, C.; Schorr-Galindo, S. Minimizing Ochratoxin a Contamination through the Use of Actinobacteria and Their Active Molecules. Toxins 2020, 12, 296. [Google Scholar] [CrossRef]
- Lad, V.; Panchal, D.; Pithawala, M.; Dwivedi, M.K.; Amaresan, N. Determination of Hemolytic Activity; Humana: New York, NY, USA, 2022; pp. 43–46. ISBN 978-1-0716-2509-5. [Google Scholar]
- Robles-Montoya, R.I.; Chaparro-Encinas, L.A.; Parra-Cota, F.I.; de los Santos-Villalobos, S. Improving Biometric Traits of Wheat Seedlings with the Inoculation of a Consortium Native of Bacillus. Rev. Mex. Cienc. Agríc. 2020, 11, 229–235. [Google Scholar]
- Carrazco, A.M.; Díaz-Rodríguez, A.M.; Parra Cota, F.I.; de los Santos Villalobos, S. Legal Framework for the Development of Microbial Inoculants. In New Insights, Trends, and Challenges in the Development and Applications of Microbial Inoculants in Agriculture; Academic Press: Cambridge, MA, USA, 2024; pp. 143–151. ISBN 9780443188558. [Google Scholar]

| Taxon Name | Strain | GenBank Accession Number | 16S Similarity (%) | Strain | ANIb | ANIm | OrthoANI | GGDC (Formula 2) (%) |
|---|---|---|---|---|---|---|---|---|
| Bacillus paranthracis | Mn5 T | MACE01000012 | 100 | Mn5 T | 97.4 | 97.81 | 97.72 | 79.3 |
| Bacillus nitratireducens | 4049 T | KJ812430 | 100 | 4049 T | 89.51 | 90.43 | 90 | 39.7 |
| Bacillus tropicus | N24 T | MACG01000025 | 100 | N24 T | 95 | 95.61 | 95.45 | 62.9 |
| Bacillus anthracis | Ames | AE016879 | 100 | Vollum T | 94.71 | 95.27 | 95.07 | 60.8 |
| Bacillus cereus | ATCC 14579 T | AE016877 | 99.92 | ATCC 14579 T | 91.35 | 92.03 | 91.78 | 45.4 |
| Bacillus albus | N35-10-2 T | MAOE01000087 | 99.92 | N35-10-2 T | 92.8 | 93.7 | 93.3 | 52.3 |
| Bacillus paramycoides | NH24A2 T | MAOI01000012 | 99.92 | NH24A2 T | 88.35 | 89.47 | 88.84 | 36.8 |
| Bacillus luti | TD41 T | MACI01000041 | 99.92 | TD41 T | 90.96 | 91.8 | 91.59 | 44.4 |
| Bacillus mobilis | 0711P9-1 T | MACF01000036 | 99.92 | 0711P9-1 T | 92.67 | 93.22 | 93.07 | 50.2 |
| Bacillus sanguinis | BML-BC004 T | MW674727 | 99.92 | BML-BC004 T | 93.37 | 94.01 | 93.83 | 54.1 |
| Bacillus paramobilis | BML-BC017 T | MW674728 | 99.92 | BML-BC017 T | 92.91 | 93.48 | 93.33 | 58.29 |
| Bacillus toyonensis | BCT-7112 T | CP006863 | 99.84 | BCT-7112 T | 90.34 | 91.28 | 90.94 | 42.8 |
| Bacillus wiedmannii | FSL W8-0169 T | LOBC01000053 | 99.84 | FSL W8-0169 T | 92.69 | 93.41 | 93.28 | 51.2 |
| Bacillus proteolyticus | TD42 T | MACH01000033 | 99.84 | TD42 T | 89.33 | 90.3 | 89.67 | 39.4 |
| Bacillus pacificus | EB422 T | KJ812450 | 99.84 | EB422 T | 95.45 | 96.09 | 95.93 | 66.2 |
| Bacillus fungorum | 17-SMS-01 T | MG601116 | 99.76 | 17-SMS-01 T | 92.84 | 93.91 | 93.53 | 53.5 |
| Bacillus arachidis | SY8 T | OM062591 | 99.76 | SY8 T | 81.35 | 85.99 | 82.21 | 26.7 |
| Bacillus pseudomycoides | DSM 12442 T | ACMX01000133 | 99.69 | DSM 12442 T | 81.48 | 86.03 | 82.23 | 26.8 |
| Bacillus hominis | BML-BC059 T | MW674729 | 99.69 | BML-BC059 T | 89.01 | 90.14 | 89.58 | 39 |
| Bacillus mycoides | DSM 2048 T | ACMU01000002 | 99.53 | DSM 2048 T | 88.82 | 89.89 | 89.44 | 38.2 |
| Bacillus gaemokensis | KCTC 13318 T | LTAQ01000012 | 99.05 | KCTC 13318 T | 81.31 | 85.83 | 82.07 | 26.5 |
| Bacillus rhizoplanae | JJ-63 T | OM391995 | 98.9 | JJ-63 T | 77.71 | 85.02 | 78.67 | 23.9 |
| Inhibition Halo Diameter (cm) | |||||
|---|---|---|---|---|---|
| Concentration | 0.02 µg/mL | 0.2 µg/mL | 2 µg/mL | 20 µg/mL | |
| Antibiotic | |||||
| Ciprofloxacin | NI | NI | 0.688 | 1.6945 | |
| Erythromycin | NI | NI | 0.818 | 1.928 | |
| Dicloxacillin | NI | NI | NI | NI | |
| Sulfamethoxazole and trimethoprim | NI | NI | NI | NI | |
| Clarithromycin | NI | NI | 1.121 | 2.487 | |
| Clavulanic acid and amoxicillin | NI | NI | NI | NI | |
| Control | TSO55 Treatment | Reduction, % | ||
|---|---|---|---|---|
| Length (cm) | Stem | 18.4 ± 2.1 a | 18.3 ± 2.2 a | 0.4 |
| Roots | 8.6 ± 1.5 a | 7.9 ± 1.6 b | 8.4 | |
| Total | 27.1 ± 2.6 a | 26.0 ± 3.0 b | 4.2 | |
| Dry weight (mg) | Stem | 18.9 ± 4.8 a | 16.8 ± 3.7 b | 11.1 |
| Roots | 29.5 ± 8.4 a | 24.0 ± 7.9 b | 18.6 | |
| Total | 0.0488 ± 0.0099 a | 0.0414 ± 0.0095 b | 15.16 |
Disclaimer/Publisher’s Note: The statements, opinions and data contained in all publications are solely those of the individual author(s) and contributor(s) and not of MDPI and/or the editor(s). MDPI and/or the editor(s) disclaim responsibility for any injury to people or property resulting from any ideas, methods, instructions or products referred to in the content. |
© 2025 by the authors. Licensee MDPI, Basel, Switzerland. This article is an open access article distributed under the terms and conditions of the Creative Commons Attribution (CC BY) license (https://creativecommons.org/licenses/by/4.0/).
Share and Cite
Campos-Avelar, I.; Montoya-Martínez, A.C.; Escalante-Beltrán, A.; Parra-Cota, F.I.; de los Santos Villalobos, S. Do Organic Amendments Foster Only Beneficial Bacteria in Agroecosystems?: The Case of Bacillus paranthracis TSO55. Plants 2025, 14, 1019. https://doi.org/10.3390/plants14071019
Campos-Avelar I, Montoya-Martínez AC, Escalante-Beltrán A, Parra-Cota FI, de los Santos Villalobos S. Do Organic Amendments Foster Only Beneficial Bacteria in Agroecosystems?: The Case of Bacillus paranthracis TSO55. Plants. 2025; 14(7):1019. https://doi.org/10.3390/plants14071019
Chicago/Turabian StyleCampos-Avelar, Ixchel, Amelia C. Montoya-Martínez, Alina Escalante-Beltrán, Fannie I. Parra-Cota, and Sergio de los Santos Villalobos. 2025. "Do Organic Amendments Foster Only Beneficial Bacteria in Agroecosystems?: The Case of Bacillus paranthracis TSO55" Plants 14, no. 7: 1019. https://doi.org/10.3390/plants14071019
APA StyleCampos-Avelar, I., Montoya-Martínez, A. C., Escalante-Beltrán, A., Parra-Cota, F. I., & de los Santos Villalobos, S. (2025). Do Organic Amendments Foster Only Beneficial Bacteria in Agroecosystems?: The Case of Bacillus paranthracis TSO55. Plants, 14(7), 1019. https://doi.org/10.3390/plants14071019

